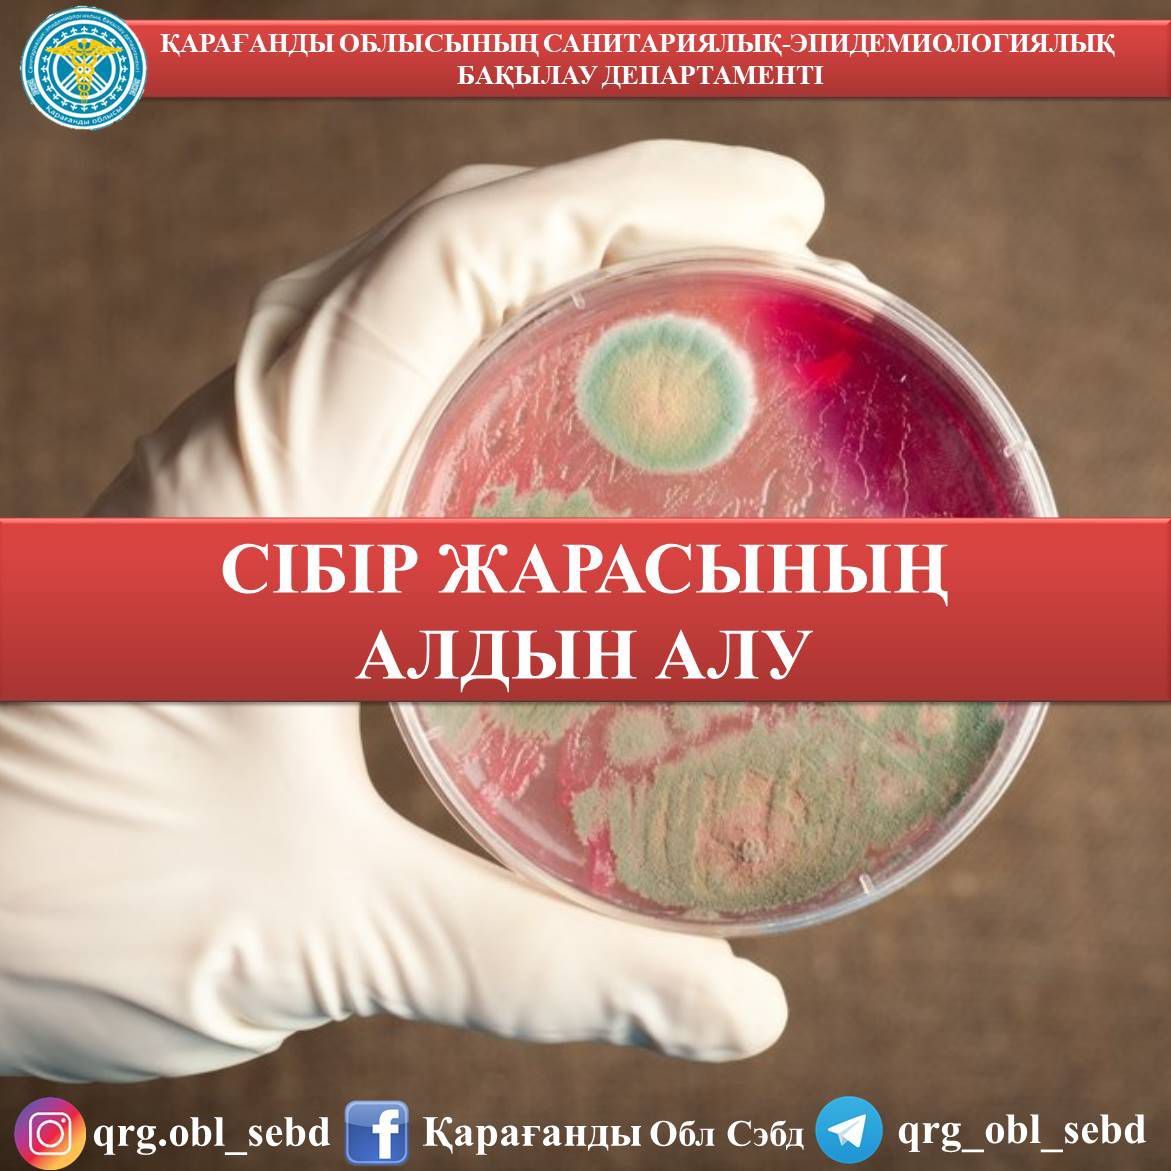
Пискалардың бір-бірін саусағындағы жеке фотосуреттері

Композицияны желіден қараңыз
Нәтижесінде кей адамдар нақты қарым-қатынас білім, мәдениет, психологиялық кеңес алу интимдік сезім маңызды болып келеді.











Нәтижесінде кей адамдар нақты қарым-қатынас білім, мәдениет, психологиялық кеңес алу интимдік сезім маңызды болып келеді.